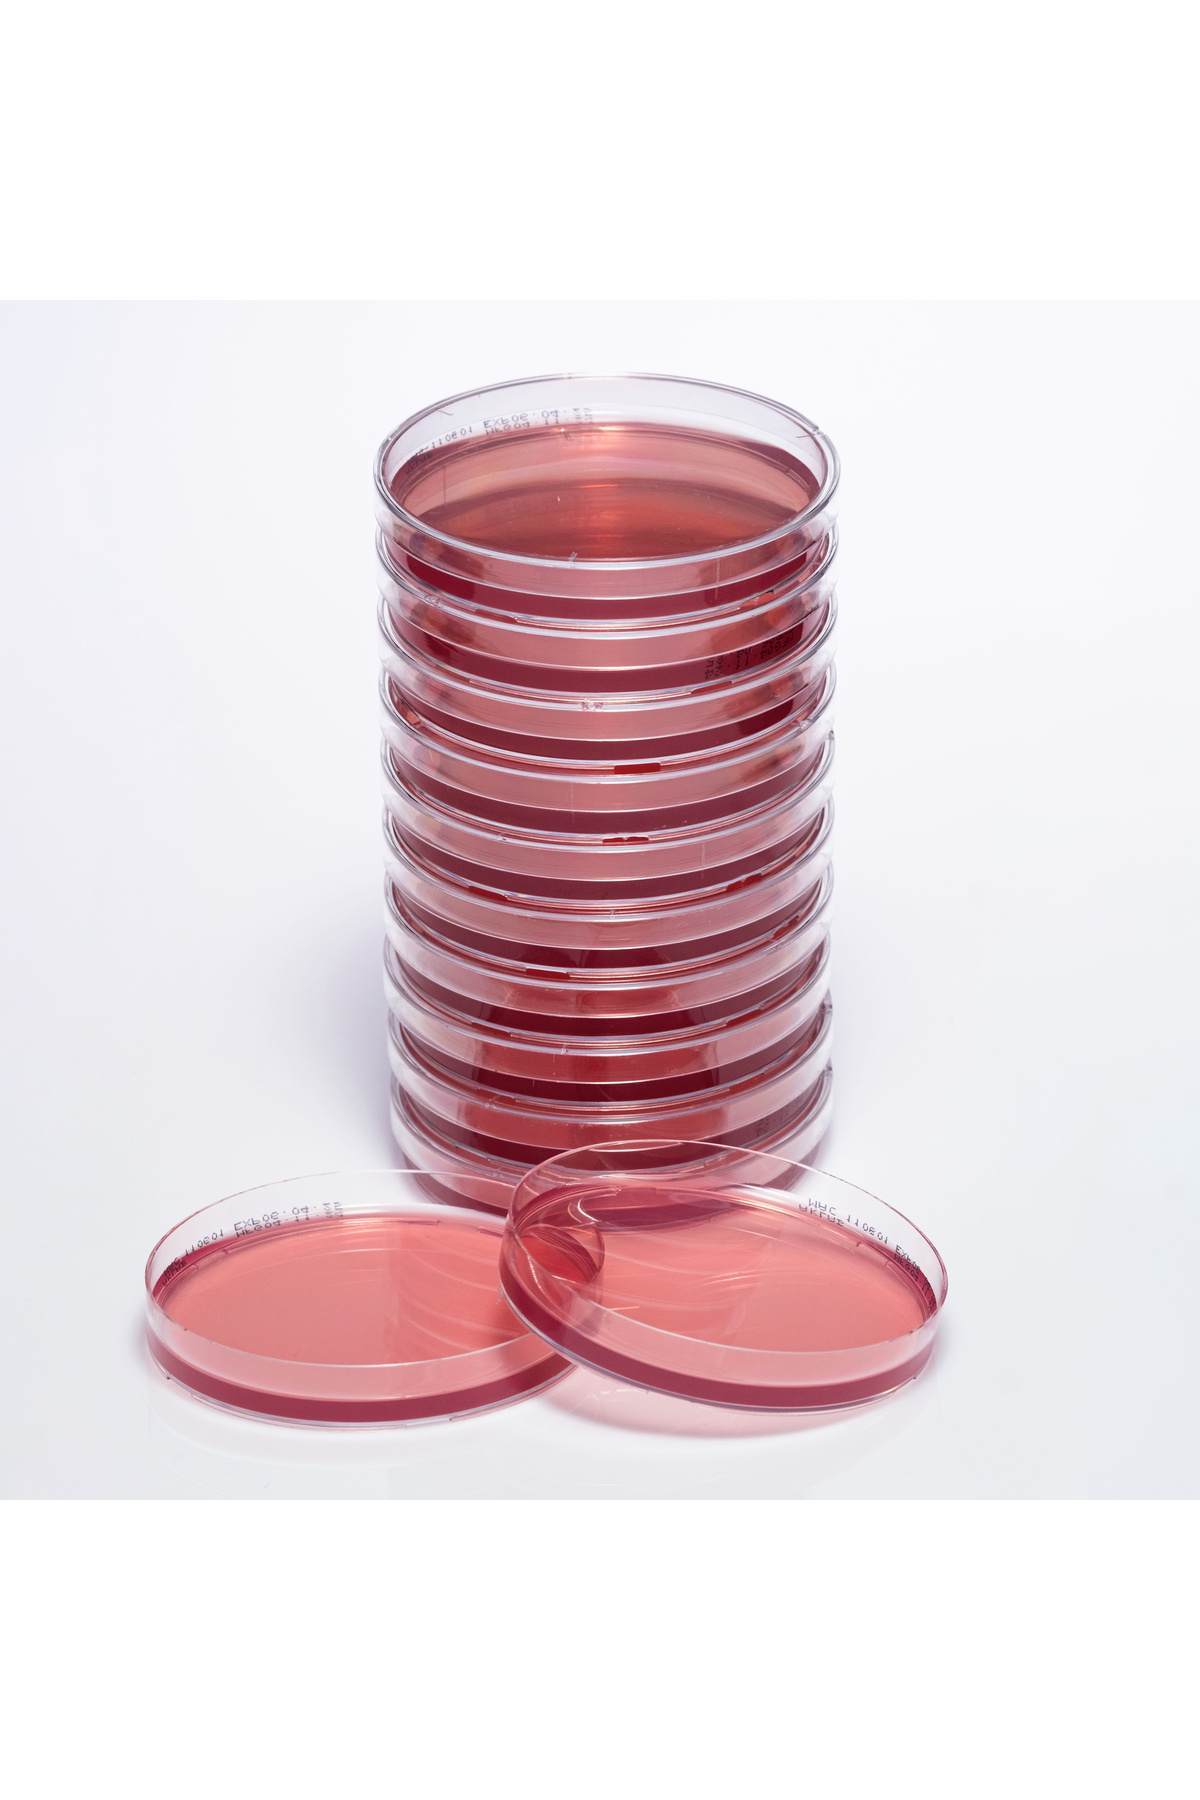

Hazır Potato Dextrose Besiyeri - 10 Adetlik Set - Soğuk Zincirli - Yüksek Kaliteli Hazır Potato Dextrose Besiyeri - 10 Adetlik Set - Soğuk Zincirli - Yüksek Kaliteli ZRHTİC4274 تک سایز
سایت مرجع :
ترندیول
فروشنده:
Zurih Lab & Zürih Ticaret
امتیاز فروشنده:
8.9
زمان تحویل در ترکبه:
5 روز
قیمت:
11,336,220تومان

 ورود | ثبت نام
ورود | ثبت نام

نظرات کاربران ترندیول